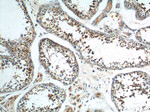
AKD1 Antibody in Immunohistochemistry (Paraffin) (IHC (P))

Search
Proteintech
AKD1 Polyclonal Antibody
{{$productOrderCtrl.translations['antibody.pdp.commerceCard.promotion.promotions']}}
{{$productOrderCtrl.translations['antibody.pdp.commerceCard.promotion.viewpromo']}}
{{$productOrderCtrl.translations['antibody.pdp.commerceCard.promotion.promocode']}}: {{promo.promoCode}} {{promo.promoTitle}} {{promo.promoDescription}}. {{$productOrderCtrl.translations['antibody.pdp.commerceCard.promotion.learnmore']}}
产品信息
23042-1-AP
种属反应
宿主/亚型
分类
类型
抗原
偶联物
形式
浓度
规格
纯化类型
保存液
内含物
保存条件
运输条件
产品详细信息
Immunogen sequence: MKERKRHLG DTKHFCPVVL KENFILQPGN TEEAAKYREK IYYFSSAEAK EKFLEHPEDY VAHEEPLKAP PLRICLVGPQ GSGKTMCGRQ LAEKLNIFHI QFEEVLQEKL LLKTEKKVGP EFEEDSENEQ AAKQELEELA IQANVKVEEE NTKKQLPEVQ LTEEEEVIKS SLMENEPLPP EILEVILSEW WLKEPIRSTG FILDGFPRYP EEAQFLGDRG FFPDAAVFIQ VDDQDIFDRL LPAQIEKWKL KQKKKLERKK LIKDMKAKIR VDTIAKRRAE LILERD (921-1205 aa encoded by BC153055 )
靶标信息
Involved in maintaining the homeostasis of cellular nucleotides by catalyzing the interconversion of nucleoside phosphates. Has both nucleoside monophosphate and diphosphate kinase activities. Catalyzes the phosphorylation of AMP, dAMP, CMP and dCMP with ATP as phosphate donor and of CMP with GTP as phosphate donor. Also catalyzes the production of ATP, CTP, GTP, UTP, dATP, dCTP, dGTP and TTP from the corresponding diphosphate substrates with either ATP or GTP as phosphate donor. Shows substrate preference of CDP > UDP > ADP > GDP > TDP.
仅用于科研。不用于诊断过程。未经明确授权不得转售。
篇参考文献 (0)
生物信息学
蛋白别名: Adenylate kinase 9; adenylate kinase domain containing 1; adenylate kinase domain containing 2; Adenylate kinase domain-containing protein 1; Adenylate kinase domain-containing protein 2; RP1-70A9.1; unnamed protein product
基因别名: AK 9; AK9; AKD1; AKD2; C6orf199; C6orf224; dJ70A9.1; SPGF89
UniProt ID: (Human) Q5TCS8
Entrez Gene ID: (Human) 221264